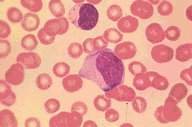

Description
Two reactive lymphocytes from a patient with infectious mononucleosis
are seen in the center of this photomicrograph. The peripheral lymphocyte
is somewhat more close to normal than the central lymphocyte. The latter
shows more characteristics of a reactive lymphocyte, such as peripheral
basophilia and some cytoplasmic streaming. There is modest red blood cell
rouleaux.
|
|
Click on this image
to enlarge it, then
on Back buttom
in the Netscape Menu
to shrink it back down



|